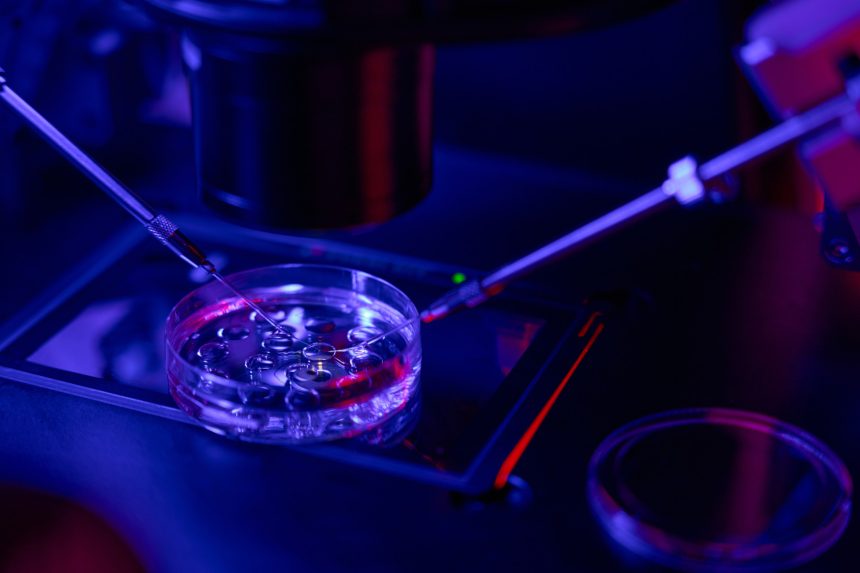
Transfer embrionale: l’ultimo passaggio della FIVET

La FIVET (Fecondazione In Vitro con Embryo Transfer) è una delle tecniche di procreazione medicalmente assistita (PMA) più diffuse e consolidate. Viene proposta alle coppie che non riescono a concepire naturalmente a causa di problemi legati all’ovulazione, alla qualità del seme, all’età o ad altre condizioni che ostacolano la fecondazione.
Nella FIVET, l’unione tra ovocita e spermatozoo avviene in laboratorio, dopo che questi sono stati prelevati dalla coppia o dai donatori.
Una volta ottenuti gli embrioni, il passo successivo è il transfer embrionale, ossia il trasferimento di uno o più embrioni nell’utero materno, dove potranno impiantarsi e dare inizio alla gravidanza.
Contatta il Professor Filicori per una consulenza sulla PMA a Bologna o Verona.
Come avviene il transfer embrionale
Il transfer embrionale costituisce l’ultimo passaggio del percorso FIVET, nonché quello più delicato. Si tratta di una procedura semplice e indolore, eseguita in ambulatorio senza necessità di anestesia (al massimo può provocare un lieve fastidio o un senso di pressione nella zona pelvica).
La paziente viene invitata a presentarsi con la vescica moderatamente piena, così da facilitare la visione ecografica dell’utero e il corretto posizionamento dell’embrione. Con l’aiuto di un sottile catetere, il medico introduce l’embrione attraverso il collo dell’utero e lo deposita delicatamente nella cavità uterina.
L’intera procedura dura in genere pochi minuti, e la paziente può tornare a casa subito dopo, senza bisogno di ricovero o convalescenza.
Cosa fare dopo l’intervento
Dopo il transfer embrionale, la paziente deve osservare alcune precauzioni:
- evitare sforzi fisici intensi, attività sportive o bagni caldi nelle ore successive;
- mantenere uno stile di vita tranquillo;
- continuare la terapia ormonale prescritta.
La paziente inoltre sarà sottoposta al consueto monitoraggio medico per verificare l’esito dell’intervento.
Quanto tempo occorre all’embrione per attecchire
Dopo l’intervento, l’embrione inizia il suo viaggio verso l’impianto: in media, l’attecchimento avviene tra il terzo e il settimo giorno dopo il trasferimento.
Le probabilità di gravidanza variano in base a diversi fattori – età della donna, qualità degli embrioni, stato dell’endometrio – ma mediamente si aggirano intorno al 30-40% per ciclo di intervento, con percentuali più alte nelle donne più giovani.
Come verificare l’inizio della gravidanza
Per capire se il transfer ha avuto successo, occorre attendere circa 12-14 giorni, quando viene eseguito un prelievo di sangue per misurare il valore della beta-hCG, l’ormone della gravidanza. Un aumento significativo di questo valore indica che l’impianto è avvenuto e che la gravidanza è iniziata.
Prenota la tua consulenza sulla PMA a Bologna o Verona con il Professor Filicori.